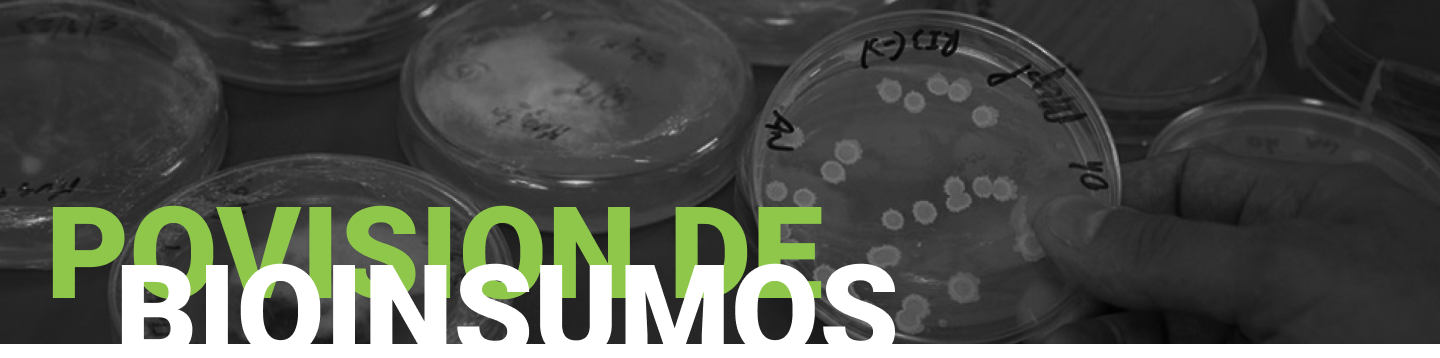

La Bioplanta de producción de insectos de ISCAMEN es una infraestructura única en su tipo en Argentina. Su diseño multipropósito y modular permite el desarrollo de diversas líneas de crías de insectos y bioinsumos como: mosca del Mediterráneo y Gusano barrenador del ganado; parasitoides e insectos utilizados como base de alimentos tal el caso del Tenebrio molitor.

Harina de Tenebrio para consumo humano y alimento de animales
Proteína alternativa con grandes beneficios; contiene ácidos grasos, fósforo, calcio, constituyendo una opción sostenible y segura tanto para la alimentación animal como humana. Además, puede utilizarse como biofertilizantes naturales o para usos biotecnológicos, farmacéuticos y cosméticos.


Pupas y adultos estériles de Mosca del Mediterráneo
Es una de las llamadas"moscas de la fruta" o moscas de los frutos,que se distribuyen en el mundo desde zonas tropicales a templadas, existiendo un registro de 4257 especies. Tanto Patagonia como los Oasis Sur y Valle de Uco de Mendoza, son áreas reconocidas internacionalmente como libres de esta plaga y sostenidas fundamentalmente a través de la liberación de machos esterilizados, producidos en la Bioplanta Santa Rosa de ISCAMEN. Además, se exporta regularmente a terceros países como Chile y Bolivia.
Cría esterilizada de mosca bichera o Gusano Barrenador del Ganado
Al alimentarse las larvas de esta mosca causan lesiones graves en la piel del ganado, los animales salvajes y los seres humanos. Los efectos son especialmente devastadores en la producción pecuaria debido a la mortalidad y a un menor rendimiento en la producción de leche y carne. Aunque se ha acabado con el gusano barrenador del ganado en los Estados Unidos, México y América Central, este sigue presente en varias zonas de América del Sur y el Caribe.


Crías del parasitoide Diachasmimorpha longicaudata.
Se trata de un parasitoide específico de moscas de la fruta, tanto para la mosca Sudamericana (Anastrepha fraterculus) como para la mosca del Mediterráneo(Ceratitis capitata Wied).
Es un tipo de avispa que con sus antenas detecta el movimiento de las larvas en el interior de las frutas, cuando éstas se encuentran en su segundo y tercer estadío, y es allí cuando introduce el ovipositor colocando uno o dos huevos en el interior de las larvas.